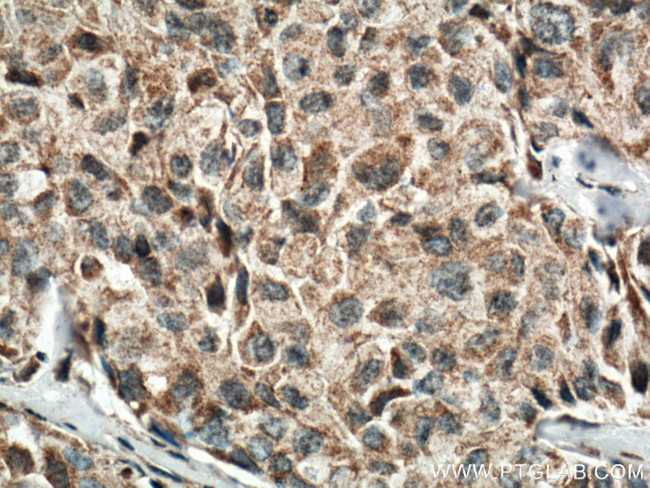
IL1 beta Antibody in Immunohistochemistry (Paraffin) (IHC (P))

Search
Proteintech
IL1 beta Monoclonal Antibody (2A1B4)
{{$productOrderCtrl.translations['antibody.pdp.commerceCard.promotion.promotions']}}
{{$productOrderCtrl.translations['antibody.pdp.commerceCard.promotion.viewpromo']}}
{{$productOrderCtrl.translations['antibody.pdp.commerceCard.promotion.promocode']}}: {{promo.promoCode}} {{promo.promoTitle}} {{promo.promoDescription}}. {{$productOrderCtrl.translations['antibody.pdp.commerceCard.promotion.learnmore']}}
产品信息
66737-1-IG
种属反应
已发表种属
宿主/亚型
分类
类型
克隆号
抗原
偶联物
形式
浓度
规格
纯化类型
保存液
内含物
保存条件
运输条件
产品详细信息
Immunogen sequence: APVRSLNCT LRDSQQKSLV MSGPYELKAL HLQGQDMEQQ VVFSMSFVQG EESNDKIPVA LGLKEKNLYL SCVLKDDKPT LQLESVDPKN YPKKKMEKRF VFNKIEINNK LEFESAQFPN WYISTSQAEN MPVFLGGTKG GQDITDFTMQ FVSS (117-269 aa encoded by B C008678)
靶标信息
Interleukin-1 beta (IL-1 beta) is a proinflammatory cytokine expressed by monocytes, macrophages, and dendritic cells. IL-1 beta is synthesized in response to inflammatory stimuli as a 31 kDa inactive pro-form that accumulates in the cytosol. Cleavage of pro-IL-1 beta into the active 17 kDa protein requires the activation of inflammasomes, which are multi-protein complexes that respond to pathogens, stress conditions, and other danger signals. Inflammasome activation triggers the processing of the caspase-1 precursor into its active form, which in turn cleaves pro-IL-1 beta. IL-1 beta lacks a signal sequence peptide for classical ER/Golgi pathway and is secreted alongside caspase-1 via an alternate and incompletely understood mechanism. Although IL-1 beta is most often secreted in its active form, secretion of the uncleaved protein may be detectable under some biological conditions. IL-1 beta signals through two receptors, IL-1RI and IL-1RII, both of which are shared with IL-1 alpha. IL-1 beta activity can be moderated by IL-1 Receptor Antagonist (IL-1RA), a protein produced by many cell types that blocks receptor binding through competitive inhibition. IL-1 beta play an important role in innate host defense by triggering the production of other proinflammatory cytokines in target cells and initiating acute-phase responses to infection and injury. Elevated levels of IL-1 beta have been associated with many chronic inflammatory conditions IL-1 beta neutralizing antibodies potential therapeutic value.
仅用于科研。不用于诊断过程。未经明确授权不得转售。
生物信息学
蛋白别名: Catabolin; Hematopoietin 1 (H1); IFN beta inducing factor; il 1b; IL 1β; IL-1 beta; IL1 B; IL1B; IL1β; ILN; Interleukin; Interleukin 1 beta precursor; interleukin 1 precursor polypeptide; interleukin 1beta; Interleukin-1 beta; Interleukin-1b; Interleukin1 beta; LAF; Osteoclast activating factor (OAF); preinterleukin 1 beta; Pro interleukin 1 beta; pro-interleukin-1-beta; unnamed protein product
基因别名: IL-1; IL1-BETA; IL1B; IL1beta; IL1F2
UniProt ID: (Human) P01584
Entrez Gene ID: (Human) 3553